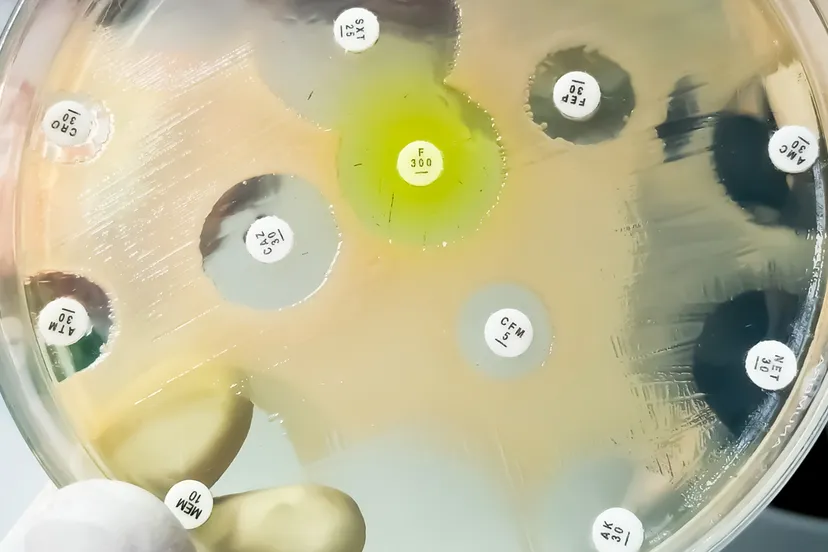
bacterieel onderzoek

Rapportage klachten over gedragingen 2023
21 mei 2024, 12:00 • Gemeente

Sittard-Geleen.nieuws.nl
Jaarlijks informeert het college van B&W de gemeenteraad over de klachten over gedragingen, die de gemeente in het voorafgaande jaar heeft ontvangen.
De behandeling van deze klachten vindt plaats met behulp van artikel 9 AWB en de eigen (door de raad) vastgestelde) regeling klachtbehandeling gemeente Sittard-Geleen 2020.
Uitgangspunt van het college is - in aansluiting op het advies van de Nationale Ombudsman - dat de klacht zo snel mogelijk in behandeling wordt genomen en waar mogelijk naar tevredenheid van de klager (informeel) wordt opgelost. Om te kunnen sturen op afhandeltijden, te leren van de klachten en de processen verder te optimaliseren wordt er per klacht informatie bijgehouden over de afhandeling.
De gemeente is volgens artikel 9 AWB wettelijk verplicht tot publicatie van de geregistreerde klachten. Met het publiceren van het klachtenoverzicht 2023 wordt aan deze verplichting voldaan. De publicatie voldoet aan de toegankelijkheidseisen met betrekking tot inclusie.
In 2023 zijn er 151 klachten over gedragingen geregistreerd. Deze hebben allemaal betrekking op werkzaamheden, die onder de verantwoordelijkheid van het college van burgemeester en wethouders worden uitgevoerd (het bestuursorgaan college van burgemeester en wethouders).
Het aantal klachten ten opzichte van de hoeveelheid inwonerscontacten is zeer gering (minder dan 0.05%, uitgaande van de voorzichtige schatting van meer dan 300.000 contacten op jaarbasis). Dat stemt het College tevreden. Niet tevreden is het College over de geregistreerde klachtafhandeltijden. De sturing hierop is inmiddels geïntensiveerd.
In april 2024 heeft de raad het Doe Mee rekenkameronderzoek klachtbehandeling behandeld. Tijdens deze behandeling heeft het college toegezegd dat de raad in het vierde kwartaal van 2024 wordt geïnformeerd over de opvolging van de aanbevelingen die op Sittard-Geleen van toepassing zijn.
Loading articles...
Loading